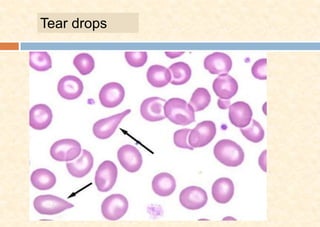
Tear drops

This document discusses different types of normocytic anemia, including anemia of chronic disease (ACD), sideroblastic anemia (SA), and aplastic anemia (AA). ACD is characterized by mild, non-progressive anemia associated with chronic inflammatory or malignant diseases. SA results from a defect in hemoglobin synthesis that causes iron to accumulate in bone marrow cells. AA is a hypoproliferative disorder defined by pancytopenia and a failure of the bone marrow to produce all blood cell types.